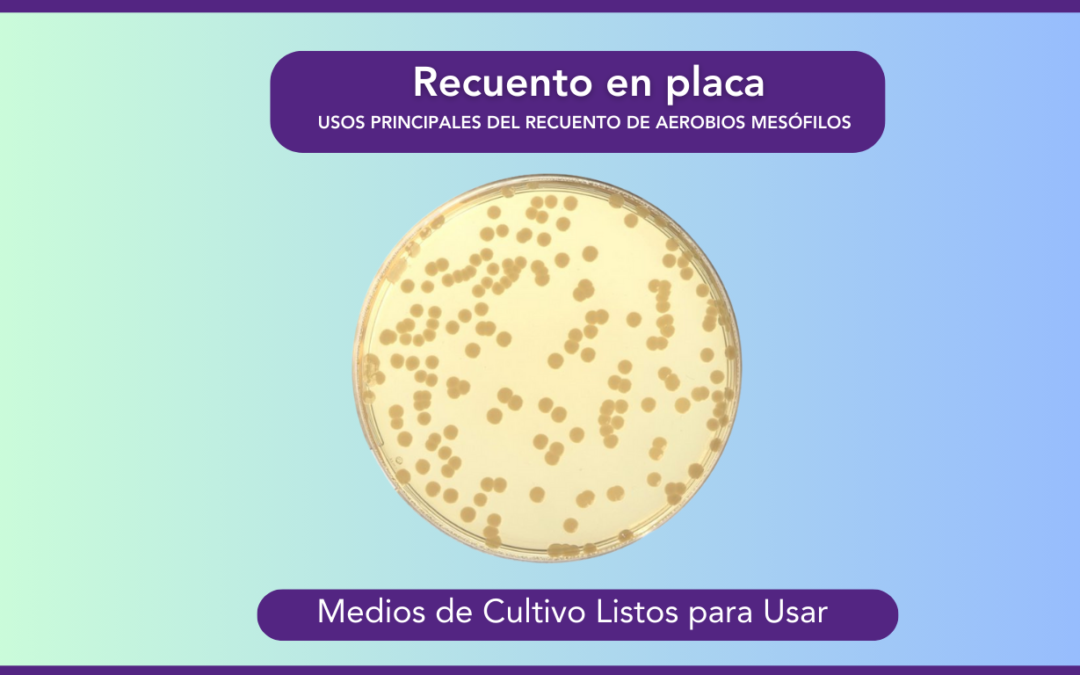

El recuento en placa es un método esencial para cuantificar bacterias aerobias mesófilas viables en diferentes tipos de muestras, como superficies, alimentos y productos farmacéuticos. Este análisis se realiza utilizando el Plate Count Agar (PCA) y se encuentra ampliamente reconocido en diversas industrias por su precisión y utilidad.
Usos Principales del Recuento de Aerobios Mesófilos.
Industria Alimentaria
Garantizar la calidad y seguridad de los alimentos es fundamental. El recuento en placa permite:
- Evaluar la calidad microbiológica.
- Verificar la higiene en procesos y entornos.
- Garantizar la seguridad alimentaria.
Industria Farmacéutica
En este sector, que se caracteriza por su múltiples regulaciones, el monitoreo microbiológico ayuda a:
- Supervisar la calidad de productos y ambientes.
- Cumplir con normativas internacionales.
Monitoreo Ambiental
A través de esta metodología, es posible:
- Controlar la presencia de microorganismos en aire y superficies.
- Prevenir la contaminación cruzada en entornos críticos.
¿Cómo Realizar un Recuento en Placa?
El método sigue la norma ISO 4833-1:2014, que especifica un procedimiento estandarizado para enumerar microorganismos en alimentos y ambientes relacionados. A continuación, presentamos los pasos clave:
- Preparación de la Muestra
- Asegúrate de que la muestra sea representativa del lote analizado.
- Prepara una suspensión inicial en un diluyente adecuado, como agua de peptona tamponada.
- Realiza diluciones decimales seriadas para obtener una serie de concentraciones.
- Siembra e Inoculación
- Pipetea 1 ml de cada dilución en placas de Petri duplicadas.
- Añade entre 12 y 15 ml de agar PCA fundido a 44-47 °C, mezclándolo cuidadosamente.
- Deja que el agar solidifique en una superficie nivelada.
- Incubación
- Incuba las placas invertidas (con la tapa hacia abajo) a 30 °C ± 1 °C durante 72 ± 3 horas.
- Este proceso evita que la condensación afecte los resultados.
- Recuento de Colonias
- Selecciona placas con 15-300 colonias, el rango óptimo para garantizar precisión estadística.
- Cuenta las colonias y calcula el número de unidades formadoras de colonias (UFC) por gramo o mililitro de la muestra.
El recuento en placa no solo asegura el cumplimiento regulatorio, sino que también es una herramienta clave para mantener altos estándares de calidad y prevenir riesgos microbiológicos.
¿Tienes dudas o necesitas más información?
Estamos disponibles en nuestras líneas de atención para brindarte el mejor soporte.
MIKROBIOL ARGENTINA
+54 9 1130273162
ventas@mikrobiol.com
MIKROBIOL LATAM
+57 310 4594786
sales@mikrobiol.com